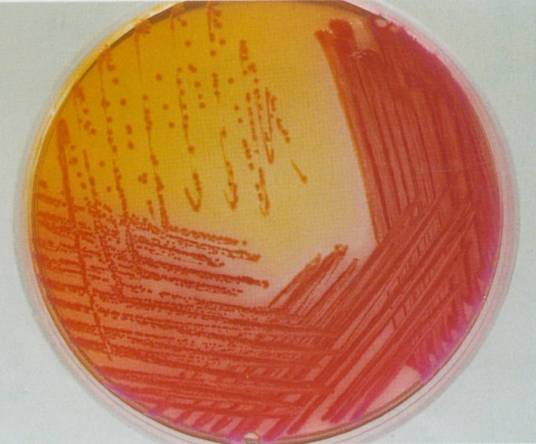

-
产气肠杆菌 编辑
产气肠杆菌 (Enterobacter aerogenes)系有膜、无芽胞、有鞭毛的革兰氏染色阴性直杆菌,在普通培养基上生长良好。能发酵多种糖类产酸产气。产气肠杆菌常存在于动物肠道、粪便、河水、土质及饲料中,可使饲料变质或营养价值破坏。
中文名:产气肠杆菌
外文名:Enterobacter aerogenes
生存于:人类和动物的肠道
最严重:败血症
菌体大小:约为长1.2-3.0μm
适应温度:15-40℃之间
产气肠杆菌主要生存于人类和动物的肠道,为人体内的正常菌群,只有在人体虚弱的特殊情况下才偶尔引起疾病。亦生存于水、土壤及腐败物中。但亦可独自生存。肠杆菌科能适应的温度范围甚广,在15-40℃之间。产气肠杆菌最适合生长于温度30℃,pH=7的环境下。
 图1 产气肠杆菌
图1 产气肠杆菌
在血琼脂平板上35℃培养18-24h,形成圆形、凸起、灰白色、不溶血的菌落。在麦康凯等培养基上形成粉红色(乳糖发酵)、较大菌落 。
氧化酶试验阴性,发酵葡萄糖、乳糖、蔗糖等多种糖类,不发酵卫矛醇,TSI为A/A。IMviC--++,动力、鸟氨酸脱羧酶、赖氨酸脱羧酶和硝酸盐还原试验均为阳性,H2S、精氨酸双水解酶试验均为阴性 。
本菌特征
发酵葡萄糖等多种糖类,IMViC--++,动力、鸟氨酸脱羧酶和赖氨酸脱羧酶试验均为阳性 。
与成团泛菌的鉴别
产气肠杆菌鸟氨酸脱羧酶和赖氨酸脱羧酶试验均为阳性,而成团泛菌则相反 。
气肠杆菌广泛存在于水、土壤等环境中,是肠道正常菌群的成员之一,又是重要的条件致病菌,可引起泌尿道感染、呼吸道感染、伤口感染以及败血症等疾病。本菌与阴沟肠杆菌一样,临床上用第三代头孢菌素治疗的过程中易产生耐药性,通常在治疗3~4日即转化为耐药株,因此,应定期重复检测菌株的敏感性 。
1、本站所有文本、信息、视频文件等,仅代表本站观点或作者本人观点,请网友谨慎参考使用。
2、本站信息均为作者提供和网友推荐收集整理而来,仅供学习和研究使用。
3、对任何由于使用本站内容而引起的诉讼、纠纷,本站不承担任何责任。
4、如有侵犯你版权的,请来信(邮箱:baike52199@gmail.com)指出,核实后,本站将立即删除。